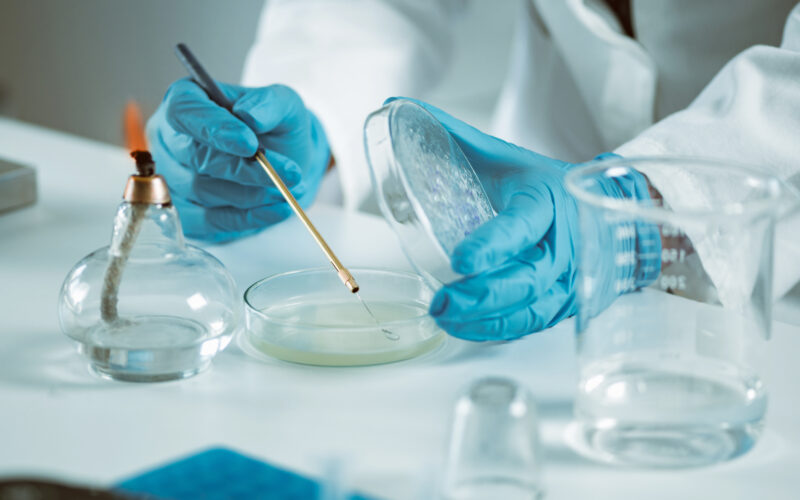

Argenx NV (NASDAQ:ARGX) is a global immunology biotechnology company founded in 2008 in the Netherlands with a mission to translate cutting-edge antibody science into transformative therapies for patients suffering from severe autoimmune diseases and cancer. The company was established by a team of scientists from the Dutch biotech sector and Belgium’s VIB (Flanders Institute for Biotechnology), leveraging the unique SIMPLE Antibody™ platform—an innovation that harnesses the naturally diverse immune systems of llamas to generate human therapeutic antibodies. Headquartered in Breda, the Netherlands, with major operations in Boston, Tokyo, and Ghent, Argenx has evolved from a small European research venture into one of the world’s most respected mid-cap biotech firms listed on both Euronext Brussels and the Nasdaq Global Select Market under the ticker symbol ARGX.
From the beginning, Argenx’s vision has centered on harnessing the immune system to modulate disease pathways more precisely and safely than traditional immunosuppressive treatments. The company’s approach focuses on antibody engineering, targeting specific cell surface receptors involved in autoimmune and oncological disorders. This scientific philosophy led to the development of its first and most successful therapy, Vyvgart (efgartigimod), a first-in-class neonatal Fc receptor (FcRn) antagonist approved for the treatment of generalized myasthenia gravis (gMG). Vyvgart represented a major scientific and commercial breakthrough for Argenx, marking its transformation from a research-focused biotech into a fully integrated biopharmaceutical company with global commercialization capabilities.
Following the success of Vyvgart, Argenx has continued to expand its clinical pipeline across multiple autoimmune indications, including chronic inflammatory demyelinating polyneuropathy (CIDP), pemphigus vulgaris, immune thrombocytopenia (ITP), and thyroid eye disease. Its subcutaneous formulation, Vyvgart Hytrulo, further demonstrates the company’s ability to innovate within established therapies, offering more patient-friendly dosing options and expanding the market reach of its FcRn inhibition platform. With ongoing regulatory filings and active commercialization in over 30 countries, Argenx has built a strong foothold in immunology and established strategic partnerships to accelerate its research and development programs globally.
In addition to its commercial portfolio, Argenx maintains a deep pipeline of next-generation antibody candidates, such as ARGX-119, a MuSK agonist for congenital myasthenic syndromes, and ARGX-213, aimed at addressing complement-mediated diseases. These programs reflect the company’s broader ambition to create a diversified portfolio of targeted immunotherapies capable of reshaping the standard of care for a wide range of autoimmune conditions. The company’s consistent investment in research, with annual R&D spending exceeding $1 billion, underscores its commitment to long-term scientific leadership in immunology and biologics innovation.
Argenx’s corporate philosophy emphasizes patient partnership and sustainable innovation. Through its “argenx for Immunology” initiative, the company collaborates closely with patient communities, clinicians, and advocacy groups to accelerate understanding and treatment of rare autoimmune diseases. This patient-centric model not only strengthens Argenx’s scientific development but also aligns its business strategy with real-world healthcare needs, earning it a reputation as one of the most trusted and forward-thinking biotech firms globally.
With over 1,000 employees worldwide and a growing presence in North America, Europe, and Asia, Argenx continues to scale its commercial and research footprint. The company’s focus on antibody engineering, data-driven clinical trials, and patient-first innovation positions it at the forefront of the next generation of immunology-based therapeutics. As Argenx moves forward, its combination of scientific rigor, strategic expansion, and sustainable growth has made it one of the most valuable biotech companies in Europe, defining its place as a leader in transforming antibody discovery into life-changing medical solutions.
Argenx Hits an All-Time High, But Risks Loom Beneath the Surface
Argenx NV (NASDAQ: ARGX) reached an all-time high of $803.95 per share, capping a remarkable 51.25% rally over the past twelve months and cementing its status as one of the strongest biotech performers of 2025. The milestone underscores investor enthusiasm around the company’s breakthrough therapies in autoimmune diseases and neuromuscular disorders, particularly the commercial success of Vyvgart (efgartigimod) and optimism surrounding its expanding clinical pipeline. The company’s financial health appears robust, with a 3.63/5 InvestingPro rating and strong free cash flow metrics, while its 88% year-over-year revenue growth signals strong demand for its flagship drug portfolio.
Yet even as the company soars to record highs, questions are emerging about whether Argenx’s valuation has run too far, too fast. Trading near its estimated fair value and carrying a market capitalization that now exceeds $45 billion, Argenx faces growing pressure to sustain its momentum. With the biotech sector notorious for volatility, one misstep in clinical development, pricing, or regulatory approval could sharply reverse fortunes.

CHECK THIS OUT: Tiziana (TLSA) Surges 143% in 2025 and Immuneering (IMRX) Reports 86% 9-Month Survival in Pancreatic Cancer.
Valuation Premium and the “Perfection Problem”
While analysts at Stifel, Oppenheimer, Truist, and BofA Securities have all reiterated Buy ratings and raised price targets as high as $918, the market may already be pricing in near-flawless execution. Argenx now trades at forward earnings and revenue multiples significantly above industry averages, suggesting limited upside unless the company exceeds expectations on multiple fronts.
The central concern for long-term investors is the sustainability of its growth trajectory. Despite the blockbuster success of Vyvgart, Argenx remains heavily dependent on a single product family for the majority of its revenue. This product concentration poses material risk in a rapidly evolving immunology market. Rivals such as UCB, Johnson & Johnson, and AstraZeneca are aggressively developing competing therapies that could pressure pricing and market share.
As of Q2 2025, Vyvgart accounted for roughly 90% of total revenue — an extraordinary level of dependency. Should competitive products enter the market sooner than expected, or if payers begin pushing back on reimbursement rates, the company’s revenue curve could flatten abruptly. Investors paying premium multiples for growth could find themselves exposed to painful valuation compression.
Pipeline Hopes Face Clinical and Regulatory Uncertainty
Argenx has touted its deep pipeline of next-generation antibody programs, including ARGX-119, ARGX-213, and ARGX-121, which target neuromuscular and autoimmune diseases. These programs promise to diversify revenue streams over the next three to five years, but the path to commercialization is fraught with challenges. The biotech sector’s history is filled with promising candidates that failed in late-stage trials, and even small setbacks in efficacy or safety could deflate Argenx’s momentum.
For instance, the company’s expansion into seronegative myasthenia gravis and chronic inflammatory demyelinating polyneuropathy (CIDP) remains under close scrutiny. While topline data has been positive, real-world outcomes and payer adoption will determine the ultimate commercial success. Moreover, regulatory agencies such as the U.S. Food and Drug Administration (FDA) and the European Medicines Agency (EMA) have become increasingly cautious with immunomodulatory therapies, adding potential delays and compliance burdens.
Even if approvals proceed smoothly, scaling these products globally will require heavy investment in marketing, distribution, and manufacturing. These expansion costs could weigh on margins, which, despite improving, remain below those of larger biotech peers.
Mounting Cost Structure and Margin Pressures
Argenx’s impressive topline growth comes at a steep cost. The company continues to channel vast sums into research and development, spending nearly $1.1 billion in FY2024 across its expanding clinical programs. In addition, general and administrative expenses have risen sharply as Argenx scales its commercial infrastructure across the U.S., Japan, and Europe.
This high-spending model, while fueling innovation, also exposes the company to profitability volatility. If revenue growth decelerates or new indications fail to deliver, Argenx’s current cost structure could rapidly compress margins. The firm’s free cash flow remains positive for now, but any misalignment between R&D outlays and realized sales could force the company to tap capital markets again — a risk investors often overlook during boom cycles.
Competitive Pressures in Autoimmune Therapeutics
Argenx operates in one of the most competitive segments in biotechnology: autoimmune and neuromuscular disorders. The company’s cornerstone therapy, Vyvgart, competes with therapies targeting the same immunoglobulin G (IgG) pathways and FcRn inhibition mechanisms. Emerging players such as Immunovant, UCB Pharma, and Johnson & Johnson are developing rival drugs that could erode Argenx’s dominance over time.
Moreover, price sensitivity in this therapeutic area is intensifying as healthcare systems globally push for cost-effectiveness. Payer negotiations, formulary positioning, and government cost-containment programs could all limit Argenx’s ability to maintain premium pricing. Even modest price erosion — compounded by rising operational costs — could materially affect earnings growth projections.
The Overconfidence Trap
Investor enthusiasm for Argenx’s clinical success has, at least for now, overshadowed realistic risk assessment. With a 51% year-to-date gain and multiple analysts projecting near-term price targets already within reach, the market appears to assume a seamless path forward. Yet biotech history repeatedly reminds investors that drug development is nonlinear, often marked by regulatory surprises, safety revisions, and competitive setbacks.
At $803.95 per share, Argenx is not just being valued for what it has achieved, but for what investors hope it will achieve. That assumption embeds considerable fragility. If even one key catalyst underdelivers — be it a missed revenue forecast, a slower-than-expected rollout of Vyvgart Hytrulo, or a clinical delay — the correction could be swift and severe.
Investor Takeaway: Great Company, Risky Entry Point
There’s no denying Argenx’s operational excellence and scientific innovation. The company has successfully commercialized a first-in-class drug, built a strong balance sheet, and earned global recognition as a leader in autoimmune therapy. But from a valuation standpoint, the stock looks increasingly vulnerable.
At current levels, Argenx embodies what investors call a “priced-for-perfection” scenario — where every positive development is already reflected in the share price, leaving minimal room for error. With costs rising, competition intensifying, and pipeline uncertainties looming, the risk-reward balance appears skewed toward caution in the near term.
Argenx’s future remains bright, but after a 51% surge and a record high at $803.95, the market may need to pause and reassess whether the company’s valuation truly reflects its long-term fundamentals or a temporary wave of biotech exuberance.
READ ALSO: Saudi Arabia Wants CEL-SCI (CVM)’s Multikine Now! and Aligos Therapeutics (ALGS) Doubles Cash to $122.9M.